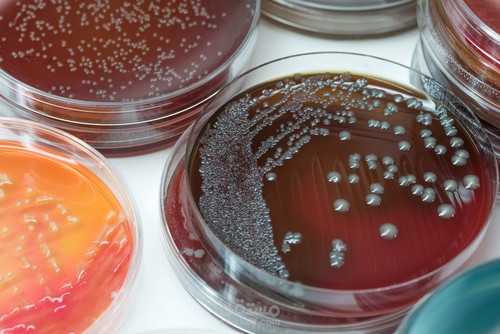
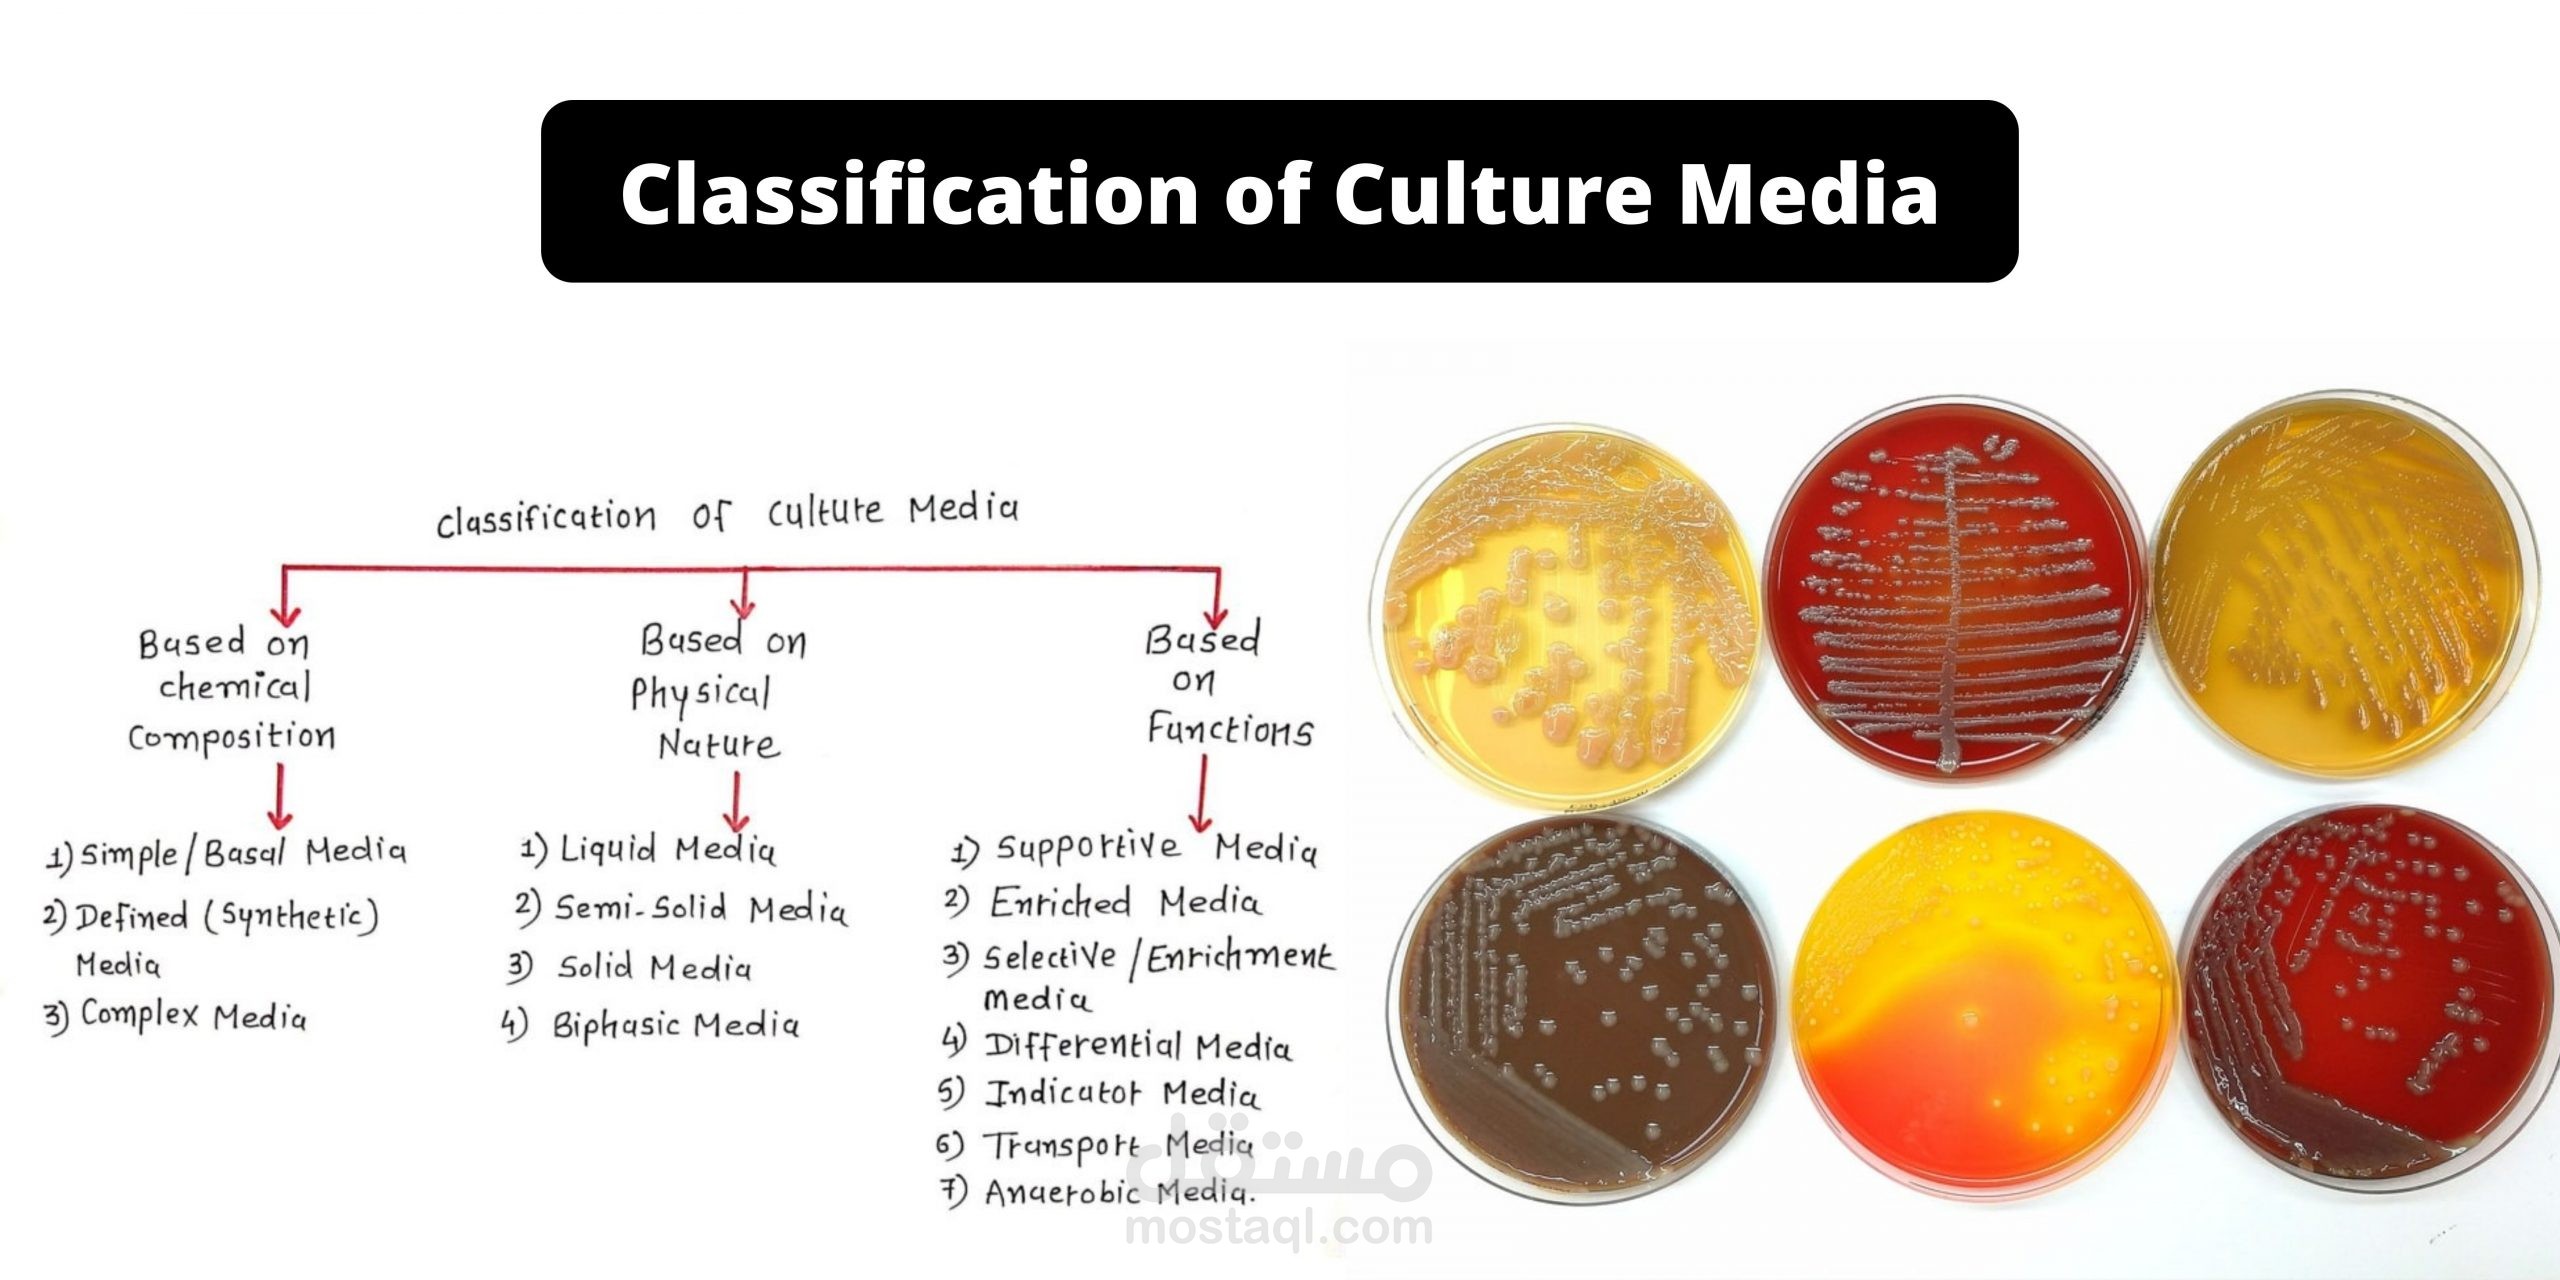

Culture media
تفاصيل العمل
Introduction, Composition, Types and Their Uses
Introduction of culture media
Media is plural while medium singular. Culture media require to grow the organisms from infected material to identify the causative agent. They are of different types on the basis using purposes. Nutrient agar(NA) uses for cultivation non-fastidious bacteria like Escherichia coli, Klebsiella pneumoniae, Pseudomonas aeruginosa where as 5% sheep blood agar (BAP) needs for Streptococcus species, Neisseria species. Chocolate agar(CHOC) is useful for culture of Haemophilus influenzae. MacConkey agar (MAC) is a selective, differential and indicator medium and uses for cultivation of Gram negative bacteria. All the organisms growing on nutrient agar, blood agar, MacConkey agar can easily grow on chocolate agar but not vice -versa.
Composition of culture media
Water is the source of hydrogen and oxygen. As electrolyte Sodium chloride or other electrolytes are necessary. Peptone is a complex mixture of partially digested protein. It contains proteoses, amino acids, polypeptides, phosphates, minerals (K, Mg) and accessory growth factors like nicotinic acid and riboflavin. Meat extract is available commercially as “Lab-Lamco”. It contains protein degradation products, inorganic salts, carbohydrates and growth factors. Blood or serum uses for enriching culture media. Usually 5-10% defibrinated sheep blood uses. In certain media, serum uses. Agar is long chain polysaccharide and prepared from sea wood (Algae –Geladium Species). It does not provide any nutrition to the bacteria but acts as a solidifying agent only. It uses in concentration of 2-3%. It melts at 98°C and solidifies at 42°C. New Zealand agar has twice jellifying capacity than that of Japanese agar.
Types of culture media
Media are of flowing types.
Based on physical state
I. Liquid media
II. Semisolid media ( Agar, 0.2-0.4% which enables motile bacteria to spread.)
III. Solid media
On the basis of presence of molecular oxygen and reducing substances in the media
I .Aerobic media and
II. Anaerobic media
Based on nutritional factors
I. Simple media
II. Complex media
III. Synthetic media and
IV. Special media
Special culture media –
a )Enriched media
b) Enrichment media
c) Selective media
d) Differential media
e) Indicator media
f)Transport media and
g) Sugar media
Simple media
Nutrient broth is an example of simple medium. It contains peptone water and meat extract 1%. when agar adds to nutrient broth, it becomes nutrient agar. This is the simplest and routinely employed medium in the laboratory for diagnostic purposes.
Complex media
All media other than simple media are complex media.
Synthetic media:
They prepare from pure chemicals and the exact composition of the medium is known. These uses for special studies such as metabolic requirements. Dubo’s medium with tween 80 is an example of a synthetic medium.
Special Media
Enriched media : When basal medium is with addition of some nutrients such as blood, serum or egg. It becomes enriched medium. For e.g. in blood agar-there is addition of blood to nutrient agar. It may use for growing a number of bacteria but one specific example is Streptococcus that requires blood for its growth. In Loeffler’s serum slope, there is addition of serum for enriching the medium. This medium uses for growing Corynebacterium diphtheriae.
Enrichment media
A fluid type of selective medium in which some substances incorporate that have either a stimulating effect on the bacteria to be grown or inhibits its competitors or both .This results in an absolute increase in the number of wanted bacteria related to other bacteria. Such medium is enrichment medium. Addition of tetrathionate in tetrathionate broth inhibits coliforms while allows typhoid-paratyphoid bacilli to grow. In selenite F broth, selenite has similar action as that of tetrathionate in tetrathionate broth.
Selective media
Selective media contain substances that inhibit all but a few types of bacteria and facilitate the isolation of a particular species. These media use to isolate a particular bacteria from specimen where mixed bacterial flora has expected. Selective media are solid in contrast to enrichment media which are liquid. Example of selective media are deoxycholate citrate agar(DCA)-Addition of deoxycholate acts as selective agent for enteric bacilli (Salmonella, Shigella) and bile salt agar(BSA). Bile salt is a selective agent. It favors the growth of only Vibrio cholerae where as inhibits the growth of other intestinal organisms.
Differential media
When a medium contains substances which help to distinguish differing characteristics of bacteria, is differential medium e.g. MacConkey’s medium, which contains peptone, lactose , agar, sodium taurocholate and neutral red. The lactose fermenters (LF) form pink colored colonies where as non lactose fermenters (NLF) produce colorless or pale colonies.
Indicator Media
These media contain an indicator which changes color when a bacterium grows in them. Salmonella enterica serotype Typhi grow as black colonies on Wilson and Blair medium containing sulphite. MacConkey ‘s medium is also an indicator medium. Due to fermentation of lactose , there is acidic pH which forms the pink colonies in the presence of neutral red indicator.
Transport media
They use in the case of delicate organisms (e.g. gonococci) which may not survive the time taken for transit or may be overgrown by non pathogenic bacteria (e.g. cholera organisms).They maintain only viability.Examples of transport media are Stuart’s transport medium: is a non nutrient soft agar gel containing a reducing agent to prevent oxidation, and charcoal to neutralize bacterial inhibitors. It may be for organisms such as gonococci. Buffered glycerol saline transport medium for enteric bacilli.
Sugar media
Sugar media help in identification of bacteria. The term sugar in microbiology denotes any fermentable substance. Glucose, lactose, sucrose and mannitol routinely employ for fermentation tests.
Anaerobic Media
These use for cultivation of anaerobic bacteria e.g. Robertson’s Cooked meat medium and thioglycollate broth.